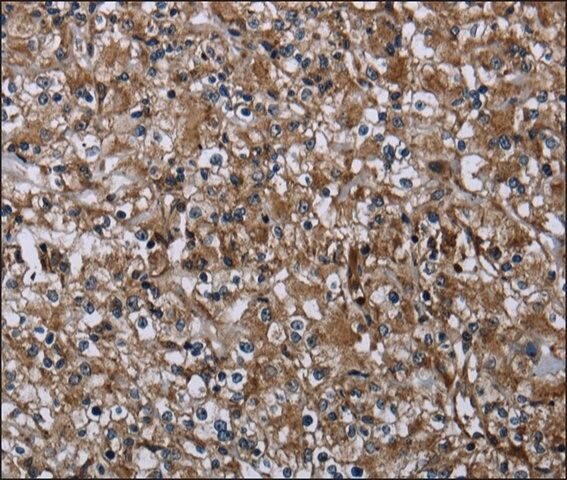

ФњЕФЮЛжУЃКЪзвГ > АыЕКbdЬхг§ЪжЛњПЭЛЇЖЫ
жааФ > Anti-FAM89B antibody produced in rabbit
АыЕКbdЬхг§ЪжЛњПЭЛЇЖЫ
жааФ
Anti-FAM89B antibody produced in rabbit
| АыЕКbdЬхг§ЪжЛњПЭЛЇЖЫ БрКХЃК | 3361716 |
| ЙцИёЃК | affinity isolated antibody |
| АќзАЙцИёЃК | 100 ІЬL |
| АыЕКbdЬхг§ЪжЛњПЭЛЇЖЫ РрБ№ЃК | НјПкЪдМС |
| ЦЗХЦЃК | Sigma-Aldrich |
| гХЛнМлЃК | СЂМДзЩбЏ |
АыЕКbdЬхг§ЪжЛњПЭЛЇЖЫ
МлИё
| АыЕКbdЬхг§ЪжЛњПЭЛЇЖЫ БрКХ | АќзАЕЅЮЛ | ЕЅМл(дЊ) | ЙњФкЯжЛѕ | ЙњЭтПтДц | бЏМлЕЅ |
| 3361716 | 100 ІЬL | 4660 |
АыЕКbdЬхг§ЪжЛњПЭЛЇЖЫ
Б№Ућ
Anti-FAM89B antibody produced in rabbit
MTVR1
ЛљБОаХЯЂ
| NACRES | NA.41 |
| SpecificityЁОЬивьадЁП | The antibody detects endogenous levels of total FAM89B protein. |
| ImmunogenЁОУтвпдЁП | Full length fusion protein |
| Features and BenefitsЁОЬиЕуКЭгХЪЦЁП | Evaluate our antibodies with complete peace of mind. If the antibody does not perform in your application, we will issue a full credit or replacement antibody. Learn more. |
| Physical formЁОЭтаЮЁП | Rabbit IgG in pH7.3 PBS, 0.05% NaN3, 50% Glycerol. |
АыЕКbdЬхг§ЪжЛњПЭЛЇЖЫ
аджЪ
| biological sourceЁОЩњЮяРДдДЁП | rabbit |
| Quality LevelЁОжЪСПЫЎЦНЁП | 100 |
| antibody formЁОПЙЬхаЮЪНЁП | affinity isolated antibody |
| antibody product type | primary antibodies |
| cloneЁОПЫТЁЁП | polyclonal |
| formЁОаЮЪНЁП | buffered aqueous solution |
| species reactivity | human |
| concentrationЁОХЈЖШЁП | 1 mg/mL |
| technique(s) | immunohistochemistry: 1:25- 1:100 |
| isotypeЁОЭЌЮЛЫи/бЧаЭЁП | IgG |
| accession no.ЁОЕЧМЧКХЁП | NP_001092254.1 |
| UniProt accession no.ЁОUniProtЕЧМЧКХЁП | Q8N5H3 |
| shipped inЁОдЫЪфЁП | wet ice |
| storage temp.ЁОДЂДцЮТЖШЁП | −20Ёц |
| Gene Information | human ... FAM89B(23625) |
АыЕКbdЬхг§ЪжЛњПЭЛЇЖЫ
ЫЕУї
| DisclaimerЁОУтд№ЩљУїЁП | Unless otherwise stated in our catalog or other company documentation accompanying the product(s), our products are intended for research use only and are not to be used for any other purpose, which includes but is not limited to, unauthorized commercial uses, in vitro diagnostic uses, ex vivo or in vivo therapeutic uses or any type of consumption or application to humans or animals. |
АВШЋаХЯЂ
| Storage Class CodeЁОДЂДцЗжРрДњТыЁП | 10 - Combustible liquids |
| WGK | WGK 1 |




